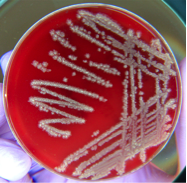

The Human Microbiome

From left to right: A transmission electron micrograph of a bacterial virus (bacteriophage), scanning electron micrograph of E. coli bacteria (artificially colored), bacteria (white) growing after being spread on a dish, edible mushrooms.
Below is a list of information found within this section:
- What are Microbes?
- What is the Human Microbiome?
- Microbiome in Human Health and Disease
- Microbiome and Cancer
- The Microbiome and Cancer Treatment
What are Microbes?
Microbes are extremely small living organisms that include bacteria and fungi. Viruses, while technically not living organisms (they require a living host to reproduce), are also considered microbes. Individual microbes cannot usually be seen with the naked eye; however, large collections of microbial cells can sometimes be seen. For example, bacteria can form visible colonies or ‘streaks’ when spread on gels containing nutrients for them. Additionally, mushrooms are reproductive structures made by some fungi, and we can certainly see the mold colonies that grow on old food. These visible structures are made up of millions of cells.
What is the Human Microbiome?
Large and diverse populations of bacteria, viruses, and fungi occupy almost every surface of the human body.1 It is estimated that there are nearly 30 trillion bacterial cells living in or on each human.2 That is about one bacterium for every cell in the human body!2 These microbes are collectively known as the microbiome.3, 1 Exposure to microbes first occurs during birth and is later influenced by environmental factors, such as diet and exposure to antibiotics.3, 1 Due to differences in environment, diet, and behavior, the specific types of microbes that make up the microbiome can vary greatly between individuals.1 It is thought that every person’s microbiome is slightly different.4 In fact, work is underway to investigate the use of microbiomes to identify individuals, much like fingerprints.4
The Microbiome in Human Health and Disease
The millions of organisms that make up the human microbiome play an important role in both health and disease. Within the human body, different types of microbes occupy specific body sites and support the functions of these organs; for example, bacteria living in the gut aid in digestion.3, 1 Environmental factors (such as diet, new microbes or antibiotics) can alter the microbiome and lead to a pro-inflammatory state. Inflammation is known to promote cancer (read more about inflammation and cancer here).
Altered gut bacteria have been linked to several diseases, including:
- Inflammatory bowel disease
- Irritable bowel syndrome
- Obesity
- Type 2 diabetes3
- Cancer
In addition to digestion, microbes are also support immune function, metabolism, and reproduction.3 While microbes play an important role in maintaining human health, they are also involved in the development and progression of some cancers. Notably, there is evidence to suggest that the microbiome can influence patient responses to cancer treatments (see details below). Scientists are now focused on understanding how microbes influence health, disease, and responses to medical treatments. Of note - some cancer treatments are dependent on inflammation and microbiome mediated inflammation can enhance the efficacy of these therapies.

The Microbiome and Cancer
Scientists are just beginning to understand the link between the human microbiome and cancer development. Initially, epidemiological (population) studies suggested certain microbes played a role in cancer. Theses studies laid the ground work for laboratory experiments, which are ongoing. While these experiments have improved our understanding of microbes in human health and disease, there is still much more to uncover. Below is an overview of the evidence which suggests microbes play a significant role in specific cancers.
Stomach Cancer
Helicobacter pylori (H. pylori), a spiral-shaped bacterium, provides one of the clearest links between a microbe and cancer development. H. pylori infections are common; the Centers for Disease Control and Prevention (CDC) estimates two-thirds of the world population carries the bacterium.5 H. pylori infections are spread by contaminated food and mouth-to-mouth contact.5 Once inside the host, H. pylori burrows into the mucous layer that lines the stomach.5 This protected area makes it difficult for the host’s immune system to clear the bacterium.5 H. pylori infections do not cause illness in most individuals; however, infection is a major risk factor for ulcers and gastric cancer.5 Population studies have shown H. pylori-infected individuals are eight times more likely to develop gastric cancer than non-infected individuals.5 The exact mechanism by which H. pylori increase the risk for ulcers and cancer is unknown.5 There is evidence, however, to suggest that long-term inflammation triggered by H. pylori infection promotes cancer development.5 The CDC recommends testing and treatment for H. pylori after removal of early stage gastric cancer and for individuals with a history of ulcers.5
Breast Cancer
In 2016 researchers identified populations of microbes living in breast tissue.6 The implications of the breast tissue microbiome are just beginning to be explored.7 Interestingly, breast tissue affected by benign and malignant (cancerous) disease was shown to have different populations of bacteria.6, 7 It is unclear if the differences in breast microbiomes helps to cause the development of tumors or is a result of the disease. In the lab, specific bacteria have been linked to tumor progression.6, 7 Mice with a predisposition to develop cancer were infected with Helicobacter hepaticus (H. hepaticus).6 Infected mice had increased mammary gland tumor burden and inflammation compared to uninfected mice.6 These results suggest that H. hepaticus can contribute to cancer progression by promoting inflammation.
Skin Cancer
The skin microbiome is diverse and differs by where on/in the body it is found.7 Experiments done in mice suggest the microbiome can have either protective or harmful roles in cancer development.7, 8 Mice treated with antibiotics (to kill their microbiome) have an increased risk of melanoma skin cancer and shorter average survival times.7, 8 These results suggest the microbiome plays a protective role against development of this cancer type. On the other side, there is also evidence that the protein ‘tails’ (flagella) of some bacteria promote chronic inflammation, leading to tissue damage and ultimately skin cancer.8 In the lab, mice were genetically modified so that they were unable to respond to bacterial flagella.8 It was found that these mice were protected against an artificially induced cancer, which indicates the inflammatory response to gut bacteria can drive the development of cancer.8

Transmission electron micrograph of a bacterium with a flagellum.
Researchers from the University of Texas MD Anderson Cancer Center in Dr. Jennifer Wargo's laboratory studies recently did sequencing on the gut and oral microbiomes of patients with melanoma. Patients had oral and gut microbiome samples taken, then were treated with anti-PD-1 therapies, and their responses were measured after 12 weeks. What they found was there were no differences in the oral microbiome between responders and non-responders, yet when they looked at the gut microbiome, they found differences between the gut microbiome of responders and non-responders. The responders to the therapy had different bacteria within the gut, which were associated with a response.9
Colorectal Cancer
In healthy individuals, the bacterium Fusobacterium nucleatum (F. nucleatum) is commonly found living in the mouth.10 Several studies, however, have found F. nucleatum in colorectal adenomas and advanced-stage colorectal cancer.10 Recently, it was found that F. nucleatum induces an inflammatory response and activation of cancer promoting genes.10 The activation of these genes was found to increase the rate of proliferation in colorectal cells.10 As described below, this organism is also involved in the development of resistance to colorectal cancer treatments.
Cervical, Anal, and Oral Cancers
Approximately 15% of all human cancers may be attributed to viruses.11 The human papilloma virus (HPV) is responsible nearly all cases of anal and cervical cancer.11 These viruses are also responsible for many cases of mouth and throat cancers.11 Interestingly, in healthy individuals, papilloma viruses are a common part of the skin and mucosal microbiotas.12 Viruses are also associated to liver cancer and skin cancer. Click here to learn more about viruses and cancer.
The Microbiome and Cancer Treatment
The impact of the human microbiome on cancer treatment is just beginning to be explored. Recent studies have highlighted the importance and potential impact of microbes on disease recovery.13, 7 Interestingly, the microbiome can support the immune system in the fight against cancer.14 For example, cyclophosphamide (a drug used to treat leukemia and lymphomas) was found to influence the microbes living in the gut.14 These gut microbes responded by promoting the creation of immune cells, which seems to enhance cyclophosphamide efficacy.14 As we have seen in the previous sections, microbes have been shown to promote cancer development by inducing inflammation. This inflammatory response can also have a beneficial impact on cancer treatments.13 Some therapies, such as platinum chemotherapy and CpG-oligonucleotide immunotherapy, are dependent on inflammation.13 Mice that were treated with antibiotics (which killed the gut micobiome) did not respond as well to platinum chemotherapy or CpG-oligonucleotide immune therapy compared to mice with intact gut microbes.13 These results suggest that the gut microbiome enhances the effects of therapies that are dependent on inflammation.13
Resistance to cancer treatments has been linked to the presence of specific kinds of bacteria in the gut. Researchers looking at drug resistance in colorectal cancer patients found an increase in Fusobacterium nucleatum in the gut. The bacterium was shown to block death (apoptosis) of the cancer cells and trigger autophagy, a survival tool for the cancer cells.15
How microbes promote immunity and affect cancer development and treatment responses is still being investigated. It is clear, however, that the microbiome can play an important role in both cancer development and treatment responses. Ultimately, researchers hope to identity and harness microbes that fight cancer and develop ways to eliminate those which promote cancer development.7
- 1abcde Ursell LK, Metcalf JL, Parfrey LW, Knight R. Defining the Human Microbiome. Nutrition reviews. 2012 Aug; 70(Suppl 1): S38-S44. [PUBMED]
- 2ab Sender R, Fuchs S, Milo R. Revised Estimates for the Number of Human and Bacteria Cells in the Body. PLoS Biol. 2016 Aug 19;14(8):e1002533. [PUBMED]
- 3abcde Cho I, Blaser MJ. The Human Microbiome: at the interface of health and disease. Nature reviews. Genetics. 2012 Mar 13; 13(4): 260-270. [PUBMED]
- 4ab Franzosa EA, Huang K, Meadow JF, Gevers D, Lemon KP, Bohannan BJ, Huttenhower C. Identifying personal microbiomes using metagenomic codes. Proc Natl Acad Sci U S A. 2015 Jun 2;112(22):E2930-8. [PUBMED]
- 5abcdefghi Helicobacter pylori and Cancer. National Cancer Institute. [https://www.cancer.gov/about-cancer/causes-prevention/risk/infectious-agents/h-pylori-fact-sheet]
- 6abcde Hieken TJ, Chen J, Hoskin TL, Walther-Antonio M, Johnson S, Ramaker S, Xiao J, Radisky DC, Knutson KL, Kalari KR, Yao JZ, Baddour LM, Chia N, Degnim AC. The Microbiome of Aseptically Collected Human Breast Tissue in Benign and Malignant Disease.Scientific Reports. 2016 Aug 3; 6: 30751. [PUBMED]
- 7abcdefgh Pevsner-Fischer M, Tuganbaev T, Meijer M, Zhang SH, Zeng ZR, Chen MH, Elinav E. Role of the microbiome in non-gastrointestinal cancers. World Journal of Clinical Oncology. 2016 Apr 10; 7(2): 200-213. [PUBMED]
- 8abcde Pfirschke C, Garris C, Pittet MJ. Common TLR5 mutations control cancer progression. Cancer Cell. 2015 Jan 12;27(1):1-3. [PUBMED]
- 9 Wargo, Jennifer. "Role of Gut Microbiome in Metastatic Melanoma Patients on Immunotherapy." Cancer Network (2017). [CANCERNETWORK]
- 10abcd Rubinstein MR, Wang X, Liu W, Hao Y, Cai G, Han YW. Fusobacterium nucleatum promotes colorectal carcinogenesis by modulating E-cadherin/β-catenin signaling via its FadA adhesin. Cell host & microbe. 2013 Aug 14; 14(2): 195-206. [PUBMED]
- 11abc McLaughlin-Drubin ME, Munger K. Viruses Associated with Human Cancer. Biochimica et biophysica acta. 2007 Dec 23; 1782(3): 127-150 [PUBMED]
- 12 Antonsson A, Forslund O, Ekberg H, Sterner G, Hansson BG. The Ubiquity and Impressive Genomic Diversity of Human Skin Papillomaviruses Suggest a Commensalic Nature of These Viruses.Journal of Virology. 2000 Dec; 74(24): 11636-11641[PUBMED]
- 13abcde Iida N, Dzutsev A, Stewart CA, Smith L, Bouladoux N, Weingarten RA, Molina DA, Salcedo R, Back T, Cramer S, Dai RM, Kiu H, Cardone M, Naik S, Patri AK, Wang E, Marincola FM, Frank KM, Belkaid Y, Trinchieri G, Goldszmid RS. Commensal bacteria control cancer response to therapy by modulating the tumor microenvironment. Science. 2013 Nov 22;342(6161):967-70. [PUBMED]
- 14abc Viaud S, Saccheri F, Mignot G, Yamazaki T, Daillère R, Hannani D, Enot DP, Pfirschke C, Engblom C, Pittet MJ, Schlitzer A, Ginhoux F, Apetoh L, Chachaty E, Woerther PL, Eberl G, Bérard M, Ecobichon C, Clermont D, Bizet C, Gaboriau-Routhiau V, Cerf-Bensussan N, et al. The intestinal microbiota modulates the anticancer immune effects of cyclophosphamide. Science. 2013 Nov 22;342(6161):971-6. [PUBMED]
- 15 Yu T1, Guo F, Yu Y, Sun T, Ma D, Han J, Qian Y, Kryczek I, Sun D, Nagarsheth N, Chen Y, Chen H, Hong J, Zou W, Fang JY. Fusobacterium nucleatum Promotes Chemoresistance to Colorectal Cancer by Modulating Autophagy. Cell. 2017 Jul 27;170(3):548-563.e16. doi: 10.1016/j.cell.2017.07.008.[PUBMED]
